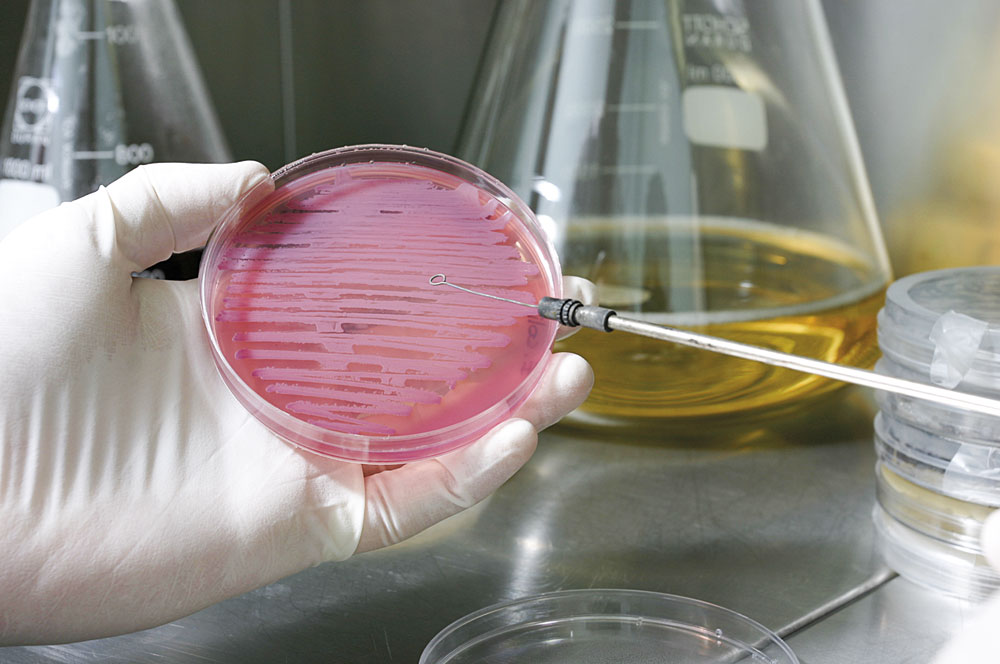

Escalando posiciones en la cordada europea
- Víctor Gardeazabal (Guía de la Innovación 2023)
- 14-Diciembre-2023

Euskadi se mantiene un año más en cabeza de la inversión en I+D en el Estado, con un 2,08% sobre el PIB, y también lidera el retorno per cápita de fondos europeos, casi triplicando la media española. Según el Regional Innovation Scoreboard (RIS) 2023, de la Comisión Europea, se sitúa entre las regiones europeas de alta innovación, tras haber crecido su rendimiento innovador un 11,5% desde 2016. Una posición destacada y confirmada en el último Panel Europeo de Indicadores de Innovación (EIS 2023). En su Informe de Innovación 2023, la Agencia Vasca de Innovación Innobasque constata que Euskadi ha mejorado su rendimiento en innovación. Todo este esfuerzo tiene su recompensa, pero la asignatura pendiente continúa siendo que este potencial innovador llegue de forma sistemática a las pymes.
La economía vasca se asienta entre las más innovadoras de Europa por la inversión empresarial en investigación, la venta de nuevos productos y un mercado laboral muy cualificado. Bajo la batuta de la Comisión Europea, el índice Regional Innovation Scoreboard (RIS) establece una clasificación que mide cuáles de los en torno a 240 territorios tienen más capacidad para impulsar la I+D y cuáles menos. Es un ranking de gran prestigio en el que tradicionalmente las comunidades autónomas españolas han estado más bien a la cola con unas pocas excepciones, entre ellas Euskadi, que, según la última actualización de 2023, vuelve a ser reconocida como la más innovadora del Estado, por delante de Madrid, Barcelona y Navarra, que también logran mejorar la media europea. La Comisión Europea califica a Euskadi como "reducto de excelencia". Este es el caso de unas pocas regiones, por ejemplo, las de Praga en Chequia y de Budapest en Hungría o las provincias autónomas de Trento, Friul-Venecia Julia o Emilia-Romaña, en Italia.
Más allá de liderar a las regiones innovadoras españolas, la mejor noticia es la gran evolución que la CAV registra de los últimos informes. Tan solo hace cuatro años, en 2019, Euskadi figuraba de color amarillo en el mapa del continente, es decir, estaba en la segunda mitad de la clasificación (puesto 132 de 238). El salto en cuatro años ha sido de 50 posiciones, hasta el puesto 72 (en el informe de 2021 estaba en la 93), lo que concede el sello de territorio altamente innovador.
El índice RIS tiene en cuenta un alto número de variables como los niveles de formación de la población, la inversión de las empresas en investigación o el volumen de publicaciones científicas y patentes. Euskadi destaca en ese sentido por contar con un nivel medio de estudios alto en comparación con el resto del continente, lo que se traduce en un mercado de trabajo integrado por puestos de alta cualificación. Se beneficia, además, de un tejido económico de marcado perfil industrial, empresas con buenos niveles de inversión en investigación y bien situadas en los mercados internacionales, a lo que se suma una potente red de parques tecnológicos para su tamaño. Otra variable relevante es la capacidad para trasladar al mercado nuevos productos, un punto fuerte en general de casi todas las comunidades autónomas españolas.
EIS 2023
El Panel europeo de indicadores de innovación -European Innovation Scoreboard EIS 2023-, alcanza un valor de 0,601 en Euskadi, superior a los 0,548 obtenidos por la UE-27 en su conjunto, debido a las buenas puntuaciones obtenidas en los bloques ‘Condiciones marco’ (0,683) e ‘Inversiones’ (0,666), según datos elaborados por el Instituto Vasco de Estadística, Eustat. La comparación que hace el Eustat del EIS 2023 señala que este dato sitúa a Euskadi al nivel del grupo de países innovadores fuertes, al obtener una media entre el 100% y el 125% de la registrada por la UE-27. Por su parte, España se coloca entre los países innovadores moderados con un valor de 0,489, 89,2% de la media europea.
El EIS 2023 trata de medir el grado en que las economías de los países tienen capacidad y desarrollan actividades de innovación. Se estructura en cuatro bloques principales de actividad, que engloban 12 dimensiones de innovación que recogen un total de 32 indicadores. En función de la puntuación obtenida y de su situación respecto a la media europea los países de la UE-27 se agrupan en cuatro categorías: líderes en innovación, innovadores fuertes, innovadores moderados e innovadores emergentes.
Por otra parte, el EIS es un panel de indicadores en continua revisión. Cada año hay variaciones tanto en los indicadores que lo forman como en su fórmula de cálculo. Estos cambios implican que no se puedan hacer comparaciones entre los distintos EIS publicados en años anteriores. En cada EIS se facilitan datos para ocho años, 2016-2023 en el caso de EIS 2023. En la primera categoría, ‘Líderes en innovación’, están los países que consiguen una puntuación superior al 125% de la media en la UE e incluye a cinco miembros: Dinamarca (0,753), Suecia (0,737), Finlandia (0,735), Países Bajos (0,705) y Bélgica (0,689), aunque en Europa el país que ocupa la vanguardia innovadora es Suiza (0,764). En el segundo grupo, ‘Innovadores fuertes’, se encuentran los que logran una puntuación entre el 100% y el 125% de la media. En este caso se hayan seis países: Austria (0,656), Alemania (0,645), Luxemburgo (0,642), Irlanda (0,634), Chipre (0,577) y Francia (0,577). Euskadi, con una puntuación de 0,601, se situaría al nivel de este grupo, entre Irlanda y Chipre, al alcanzar el 109,7% de la media de EU-27. Al tercer grupo, ‘Innovadores moderados’ (entre el 70% y el 100% de la media), pertenecen diez países; por orden de puntuación: Estonia, Eslovenia, Chequia, Italia, España, Malta, Portugal, Lituania, Grecia y Hungría, con valoraciones que oscilan entre el 0,540 de Estonia y el 0,385 de Hungría. Por último, en el cuarto grupo, ‘Innovadores emergentes’ (menos del 70% de la media), se sitúan seis países. En orden decreciente: Croacia, Eslovaquia, Polonia, Letonia, Bulgaria y Rumanía, al obtener puntuaciones entre 0,381 el primero de ellos y 0,181 puntos el último. En este sentido, la C.A. de Euskadi sobresale en dos bloques respecto a la media europea: en ‘Condiciones Marco’ e ‘Inversiones’. 
Se mantiene el gasto en I+D
Los datos del EIS 2023 confirman el esfuerzo que se está llevando a cabo en Euskadi en actividades de investigación científica y desarrollo tecnológico en los últimos años. Según el Eustat, el gasto en I+D superó en 2022 un año más el máximo histórico al crecer un 9% y alcanzar los 1.795 millones de euros. Con estas cifras, el gasto en actividades de I+D sobre el PIB representaba en 2022 el 2,08%, ligeramente inferior al del año anterior (2,11%). En 2022, la I+D interna empleó a 21.746 personas en Equivalencia a Dedicación Plena (EDP), al aumentar el 4,5% respecto al año anterior. Asimismo, el personal investigador, supuso 15.230 personas en EDP, tras mejorar el 6,0%. Al igual que el gasto, ambas cifras, personas en EDP y personal investigador, constituyen cifras récord.
Bajando al detalle territorial, se constata que en 2022 el 45,6% del gasto total en I+D interna de la comunidad se llevó a cabo en Bizkaia, el 43,3% en Gipuzkoa y el 11,1% en Álava. En relación al PIB de cada territorio, hay que señalar que este gasto representa el 2,75% del de Gipuzkoa, el 1,83% del de Bizkaia y el 1,49% del de Álava.
En cuanto al sector de ejecución del gasto en I+D interna, la mayoría, el 77,1% (1.384,5 millones de euros), lo llevaron a cabo las empresas, mientras que el 16,4% (294,3 millones) correspondió a la enseñanza superior y el 6,5% restante (115,9 millones) lo ejecutaron diversos organismos dependientes de la Administración. En relación a 2021, las empresas incrementaron un 8,6% su gasto en I+D, un 10,7% los organismos y un 10,2% la enseñanza superior.
Desde la óptica de la financiación del gasto en I+D interna, las empresas destinaron a investigación 1.004 millones de euros, un 7,6% más que en 2021. Esta cifra supone el 55,9% del total de la financiación, aunque disminuye su participación en el total financiado en 0,8 puntos porcentuales con respecto al año anterior. Aun así, se mantiene como la primera fuente de financiación. La financiación pública, por su parte, aportó 608 millones, tras aumentar un 12,4% respecto al año anterior, y representa el 33,9% del total del gasto en I+D interna, con lo que incrementa su presencia en un punto porcentual.
PCTI 2030
En 2022, el 36,9% del personal total de I+D en dedicación plena eran mujeres. Son 8.033, tras un aumento de un 6,6% en relación al número de mujeres dedicadas a I+D el año 2021. Su peso en el total del personal aumenta siete décimas de punto y, desde una perspectiva temporal más amplia, su peso se incrementa 3,5 puntos porcentuales en relación al año 2010 y hasta 10,3 puntos sobre el año 2000. Los fondos públicos del Gobierno vasco tienen un carácter tractor que busca ejercer de palanca de la inversión privada con el fin de alcanzar los niveles europeos en materia de inversiones en I+D. De acuerdo con este principio, los presupuestos de apoyo a la I+D+i han crecido más de un 10% de promedio en los ejercicios 2021, 2022 y 2023, por encima del 6% comprometido en el Plan de Ciencia, Tecnología e Innovación PCTI Euskadi 2030. El Ejecutivo autónomo trabaja para dar continuidad a este esfuerzo inversor, porque entiende que se trata de una apuesta estratégica de futuro para Euskadi. En esta línea, en 2023 ha incrementado un 12% sus partidas de apoyo a la I+D+i, hasta alcanzar los 658,5 millones de euros, una cifra récord. El próximo año y partiendo de esta cifra, se quiere hacerla crecer en más de 42 millones, hasta sobrepasar los 700 millones en total, tal y como figura en el proyecto de presupuestos presentado en el Parlamento.
Los fondos públicos del Gobierno vasco tienen un carácter tractor que busca ejercer de palanca de la inversión privada con el fin de alcanzar los niveles europeos en materia de inversiones en I+D. De acuerdo con este principio, los presupuestos de apoyo a la I+D+i han crecido más de un 10% de promedio en los ejercicios 2021, 2022 y 2023, por encima del 6% comprometido en el Plan de Ciencia, Tecnología e Innovación PCTI Euskadi 2030. El Ejecutivo autónomo trabaja para dar continuidad a este esfuerzo inversor, porque entiende que se trata de una apuesta estratégica de futuro para Euskadi. En esta línea, en 2023 ha incrementado un 12% sus partidas de apoyo a la I+D+i, hasta alcanzar los 658,5 millones de euros, una cifra récord. El próximo año y partiendo de esta cifra, se quiere hacerla crecer en más de 42 millones, hasta sobrepasar los 700 millones en total, tal y como figura en el proyecto de presupuestos presentado en el Parlamento.
Estas inversiones están permitiendo impulsar actuaciones en los tres pilares del PCTI Euskadi 2030: excelencia científica, liderazgo tecnológico industrial e innovación abierta, así como en el talento necesario para garantizar su desarrollo. También apoyar el desarrollo de grandes proyectos emblemáticos de I+D+i en colaboración público-privada y aplicados en las áreas prioritarias de especialización inteligente. Frente a un escenario de incertidumbre y ralentización económica, el Gobierno mantiene su compromiso con la reactivación económica y la generación de oportunidades de empleo. Un empleo de calidad en sectores intensivos en conocimiento, basados en la investigación y la innovación.
Proyectos europeos
El PCTI Euskadi 2030, cuyo objetivo es situar al País Vasco entre las regiones europeas más avanzadas en innovación en 2030, avanza con mejoras en 11 de los indicadores de su Cuadro de Mando, según el primer informe de seguimiento del mismo, elaborado con la colaboración de la Agencia Vasca de la Innovación, Innobasque, y presentado en una reunión del Consejo Vasco de Ciencia, Tecnología e Innovación. “Tenemos la firme convicción de que la investigación y la innovación contribuirán decisivamente a afrontar los retos de futuro”, afirmó el lehendakari Iñigo Urkullu. Destacó, asimismo, que “nuestra posición actual es buena, ya que Euskadi se mantiene entre las regiones y países de Alta Innovación y es la primera Comunidad Autónoma del Estado en inversión en I+D, en innovación empresarial y en retorno de fondos europeos”. Entre estas mejoras, el informe destaca el crecimiento en las inversiones de I+D y su impacto en el empleo intensivo en conocimiento. En la potenciación de la internacionalización de la I+D+i vasca, las publicaciones científicas en colaboración alcanzaron las 1.953.
El balance del PCTI Euskadi 2030 también hace referencia a la participación de Euskadi en Horizonte Europa, el programa marco de investigación e innovación de la Comisión Europea. La CAV logró excelentes resultados en Horizonte 2020 (H2020). vigente de 2014 a 2020, y confía en repetirlos en la nueva convocatoria del programa. Como su predecesor, Horizonte 2021-2027 busca consolidarse como el instrumento fundamental para llevar a cabo las políticas de I+D+I de la UE. El objetivo general del mismo es alcanzar un impacto científico, tecnológico, económico y social de las inversiones de la UE en I+I, fortaleciendo de esta manera sus bases científicas y tecnológicas y fomentando la competitividad de todos los Estados Miembros.
Con un presupuesto de 95.517 millones de euros (en precios corrientes) para este periodo de siete años, Horizonte 2021-2027 se convierte en el Programa Marco con el mayor presupuesto hasta la fecha, teniendo el potencial de generar importantes beneficios económicos, sociales y científicos. Se estima que Horizonte Europa generará 11 euros en ganancia del Producto Interior Bruto (PIB) por cada euro invertido, creará hasta 320.000 nuevos puestos de trabajo altamente cualificados para el año 2040 y consolidará el liderazgo de Europa en Investigación e Innovación. El programa está diseñado con una mentalidad de inversión más que como un instrumento exclusivamente de financiación, y contará con una planificación que ayudará a la UE a realizar la transición hacia un futuro próspero y sostenible.
Tras el lanzamiento en 2021 de Horizonte Europa, en 2022 se comenzaron a firmar los primeros contratos. En ese año se aprobaron 333 nuevos proyectos europeos que contaron con participación vasca y que supondrán un retorno de casi 230 millones de euros para Euskadi. Se ha multiplicado por tres el número de proyectos y por 4 la financiación respecto al año anterior. Destaca el elevado porcentaje de éxito de las propuestas con participación vasca en el programa, que alcanzó el 23,8%, notablemente superior a la media europea del 16,64% o a la del Estado del 19,26%. En los 333 proyectos se dio la participación de 523 entidades vascas, en su mayoría organizaciones de investigación (54%), seguidas de las empresas y otras entidades con ánimo de lucro (29%) y de las entidades de enseñanza superior (11%).
El consejero de Economía y Hacienda, Pedro Azpiazu, ha calificado el año 2023 como “un momento clave para el Gobierno vasco, pero también para el conjunto de instituciones y agentes empresariales, científico-tecnológicos y sociales vascos”.
Investigación científica
Euskadi ha superado por primera vez las 22.000 personas dedicadas a investigación y en 2022 invirtió 1.800 millones de euros en I+D y captó 240 millones de euros de un programa europeo, cifras que sitúan a la CAV como la primera de España en esos indicadores, según el Informe de Ciencia Euskadi 2023, presentado el pasado 15 de noviembre por el consejero de Educación del Gobierno vasco, Jokin Bildarratz, y el director científico de Fundación Vasca para la Ciencia, Ikerbasque, Fernando Cossío. Según este informe, el País Vasco invirtió 1.800 millones de euros en actividades de I+D en 2022, un “máximo histórico” que supone un 9,1 % más que el año anterior y un 2,3 % del PIB, con lo que se convirtió en la comunidad con más inversión en este terreno, por delante de Madrid, Navarra y Cataluña. Euskadi ocupa también el primer puesto de las CC.AA. en cuanto a retorno per cápita del programa europeo Horizon, herramienta clave para las actividades de investigación en la UE, con la captación de 240 millones de euros entre 2021 y 2022. En 2021, superó por primera vez las 22.000 personas dedicadas a labores de investigación, lo que supone que más del 2 % de la población activa vasca se dedica total o parcialmente a esta ocupación, y es la comunidad también líder en este indicador.
Euskadi ocupa también el primer puesto de las CC.AA. en cuanto a retorno per cápita del programa europeo Horizon, herramienta clave para las actividades de investigación en la UE, con la captación de 240 millones de euros entre 2021 y 2022. En 2021, superó por primera vez las 22.000 personas dedicadas a labores de investigación, lo que supone que más del 2 % de la población activa vasca se dedica total o parcialmente a esta ocupación, y es la comunidad también líder en este indicador.
El informe de Ikerbasque destaca que las publicaciones científicas de los investigadores vascos fueron 7.818 en 2022, una producción ligeramente inferior a la del año anterior -7.846 artículos- y un 14 % superior a la registrada antes de la pandemia. En 2023 y 2024, la Fundación Vasca para la Ciencia espera que se superen las 8.000 publicaciones. La Universidad del País Vasco (UPV/EHU) continúa como la principal institución científica vasca, con una aportación de unas 4.500 publicaciones en 2022. En su conjunto, las universidades vascas aglutinan el 65 % de la producción científica total de Euskadi, seguidas del sector sanitario, los Centros de Investigación Vascos de Excelencia (BERC, por sus siglas en inglés), centros tecnológicos y los CIC.
Hazinnova
Si pasamos a la innovación no tecnológica, el pasado 26 de octubre se cerró la convocatoria 2023 del programa de innovación no tecnológica Hazinnova, que este año, como novedad, se ha abierto a empresas que hayan sido beneficiarias de los programas Innobideak y/o Hazitek. Hazinnova, que en 2023 ha contado con un presupuesto asignado de 2,7 millones de euros, facilita que pequeñas y medianas empresas vascas implementen microproyectos de innovación no tecnológica, centrada en producto y en procesos de negocio en áreas como fabricación, logística, comercialización, administración o finanzas.
En la última edición de Hazinnova, la tercera, participaron un total de 321 pymes vascas. A través de la convocatoria Hazinnova 2022, y con el objetivo de ser más competitivas, estas empresas han ejecutado un total de 410 proyectos de microinnovación en distintas áreas. En la convocatoria de 2022, el programa contó con una dotación de 2.760.000 euros y desde su implantación en 2019, ha beneficiado ya a 657 empresas vascas. or territorios, en Hazinnova 2022 participaron 156 empresas en Bizkaia (225 proyectos), 118 en Gipuzkoa (121 proyectos) y 47 en Álava (64 proyectos). Todas ellas son pymes de entre 5 y 99 personas empleadas, con su centro de actividad en Euskadi y pertenecientes a los sectores de industria (manufacturera, gestión de aguas y residuos, suministro de energía, etc.) o servicios (actividades TIC, transporte o comercio mayorista, entre otros). Algunas de ellas son recurrentes, es decir, han participado en convocatorias Hazinnova anteriores.
El compromiso de pequeñas y medianas empresas por el impulso de la innovación ha sido clave para que en 2022 Euskadi haya superado por segundo año consecutivo la media europea del índice de innovación (este año en un 10%) y se haya incorporado además al grupo de países ‘innovadores fuertes’ de la UE.
Informe Innobasque de Innovación 2023
Todo ello hace que se constate que Euskadi ha mejorado su rendimiento en innovación en el Cuadro Regional de Indicadores de Innovación de la Comisión Europea, tal y como se recoge en la última edición del Informe Innobasque de Innovación 2023. Este informe, que cada dos años publica Innobasque, recoge un extenso análisis de fuentes vascas, estatales y europeas. De este modo se monitoriza el Sistema Vasco de Ciencia, Tecnología e Innovación, rol que el Plan de Ciencia, Tecnología e Innovación Euskadi 2030 encomienda a Innobasque y que tiene por objetivo situar Euskadi como una referencia de la innovación europea.
En esta cuarta edición, el documento analiza los últimos datos estadísticos disponibles, de 2021, ejercicio en el que la inversión vasca en I+D fue de 1.647 millones de euros, lo que implica un crecimiento del 10,5% con respecto a 2020. Se trata de una cifra récord que evidencia el dinamismo de la innovación en Euskadi. Estos números consolidan una tendencia alcista iniciada en 2016 que previsiblemente, según estimaciones de la Agencia Vasca de la Innovación, Innobasque en su "Estimación de la inversión de Euskadi en I+D”, publicada a principios de 2023, se consolidará durante los dos próximos ejercicios con cifras que podrían llegar a 1.768 millones en 2022 y 1.895 millones en 2023.
Esta tendencia contrasta con lo ocurrido en crisis anteriores, en las que las inversiones en I+D vascas se reducían. Este cambio de comportamiento refleja la mayor importancia estratégica que las empresas vascas otorgan a la innovación, considerándola un elemento clave para su competitividad. También se ha visto apoyado por las medidas excepcionales de recuperación adoptadas por la Unión Europea que han provocado la aceleración de la transformación en sectores clave de la economía vasca, así como por el decidido apoyo del Gobierno vasco que ha incrementado su presupuesto de apoyo a la I+D+i en torno al 10% en los últimos años.
Euskadi, considerada “polo de excelencia” por la Comisión Europea, escala desde la posición 93 a la 72 de las 239 del Cuadro Regional europeo de Indicadores de Innovación, siendo la comunidad autónoma mejor posicionada del Estado. Tomando como referencia el nivel de rendimiento en innovación de la UE en dicho cuadro de indicadores y asignándole un valor 100, Euskadi se está en el nivel 109,8 frente al 106,6 de Madrid, el 105,9 de Cataluña y el 101,8 de Navarra, que son las otras tres comunidades de alta innovación del Estado.
Desde el punto de vista de los resultados, que en el caso de la innovación son fruto de inversiones en años anteriores, cabe destacar que, a nivel estructural, Euskadi ha logrado incrementar el nivel tecnológico de las exportaciones industriales. Así lo refleja el peso de las exportaciones de sectores industriales de nivel tecnológico medio-alto, que desde 2014 ha ido aumentando paulatinamente hasta alcanzar cerca del 50% en 2021, en detrimento de las exportaciones de los sectores de medio-bajo nivel tecnológico.
En la actualidad son innovadoras el 76,6% de las grandes empresas, el 60,4% de las medianas y el 35,9% de las pequeñas; es decir, el 40,5% de las empresas vascas es innovador. Además, estas empresas han invertido más que sus homólogas europeas, concretamente un 4,5% sobre su facturación, respecto al 3% de media europea. De ese 4,5%, el 3,4% corresponde a I+D y el 1,1% restante a otras actividades innovadoras como ingeniería, marketing, gestión de la propiedad intelectual e industrial o adquisición de maquinaria.
Todo este esfuerzo innovador tiene su recompensa. Euskadi ha logrado atraer en los últimos años proyectos empresariales de calado, caso de Basquevolt, el ordenador cuántico de IBM o diversos proyectos pioneros de generación renovable como el aerogenerador gigante flotante DemoSATH, de Saitec y RWE, que ya suministra energía eléctrica desde su emplazamiento a dos millas de la costa vizcaína.









